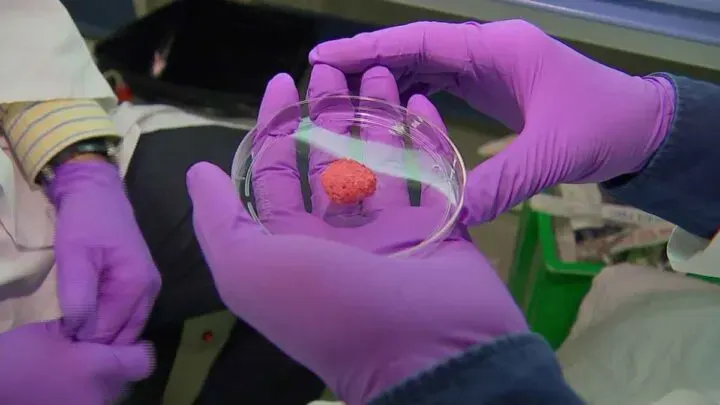
vocus|新世代的創作平台

再生漢堡、生化人運動賽?人類描繪的藍圖
「我知道我的未來不是夢,我認真的過每一分鐘。」已故歌手張宇生所演唱的《我的未來不是夢》相信許多六、七年級生還耳熟能詳。而人類的或是世界的未來會怎麼樣?其實一直以來是很多人感興趣的地方,但複雜的局勢與新的挑戰出現,我們會更好或更糟糕,科學與設計可能會稍稍看見些答案。
《未來的》是一部以現在人們所掌握的科學科技創新技術,來想像未來人類的藍圖,用輕鬆幽默的方式呈現讓觀眾知道有可能是未來的趨勢、或是一項假說和挑戰,來推測人類未來的生活會是什麼樣子的雛型。有些你可能早早預料,但有更多未來可能在你預料之外。

《未來的》是什麼節目?
過去20世紀的科幻電影中許多酷炫的產品,到了現在一件一件被實現,二戰時期塞滿一整棟房的高能處理器,如今成了家家戶戶都有的桌上電腦,資料不用存放在上鎖的櫃子,而是加設密碼的網路雲端上。這種人類習慣的改變算算都不超過百年,就改變你我的行為生活。
誰能料到笨重的電話演變到今,變成可以隨身帶走通話、社交、追劇等讓你生活更加方便的存在,而這也只是當代十多年的事情。這也表示,在人類的未來依舊有著越來越多可能性,等待研究和去克服,而且連帶著不只科學,環保與醫療甚至動植物都在這「未來式」的環節之中。
以單元劇為主的節目紀錄片《未來的》是一個試想人們未來生活是怎樣的型態,利用我們現在仍在研發研究,甚至努力想達到的方向去做聯想,讓我們看到它十年、二十年、甚至百年之後實用於生活的模樣。
可以用耳機聽懂你家寵物說什麼、生化科技讓運動傷害降到最低、交友軟體不只配對人還能安排你的命中注定、讓人類細胞與器官自動修復減少醫療支出等等,多種由當代許多科學家與設計師正在努力的開發項目中,去推斷如果未來這些都成真會是怎樣美好的世界。

《未來的》分析與延伸:
關於「未來」這概念最重要的其實不是科學而是哲學。這來於人們透過現在或過去的模型,運用大腦的想像力,邏輯和歸納法則。在符合自己所思考與能掌握的狀態下推測「可能合理」的結果,但是這結果還沒發生,只是替你當下提供一條「之後可能有用的訊息」。
關於未來其中之一是統計學,例如我們可以成過往地震或颱風的行程來推斷,之後可能會產生多大的震度的地震;風速雨量多大的颱風。人腦袋中會因為過去的經驗,想像可能會發生的事情,故未來是你大腦中對事情「降低你風險的評估」,並提供有用的訊息,當然有時候會出錯或是自己本身就知道癡人說夢,那就並非未來,而是作夢。


故未來其實是一種具有想像力、創意的富有邏輯的規劃,每個人應該都對未來有著不同想像,但很有意思的是,有些科學或哲學研究者發現,在網路時代或多元時代因為資訊流通量大且發達,反而僵化統一了許多人對未來的想像,尤其是影視娛樂讓許多受眾把未來設定成一個單一模組、像是套版的通俗科幻小說。
這種所有人都統一想像的未來樣貌,其實是一種想像力的僵化,它不只反應在大眾娛樂上,也反應在國家政策與社會,還有你的生活上。如果人類缺少了對未來的想像,很可能連帶發生嚴重的心理問題,更可能導致人類科技的停滯與服從少數人掌握下的「未來生活」。

《未來的》值得一看嗎?
其實我覺得《未來的》這個紀錄節目算是對於人類未來相當樂觀的一種看法,裡面雖然也會敘述許多關於這種想法帶來的壞處甚至隱憂,但多半還是樂見其成,是一種正向的未來想像,所以感覺很適合來寓教於樂。
但老實說這種太正面的未來憧憬只是個概念,我覺得整部《未來的》最主要的缺失是它都是以科學的角度出發,並沒有從人類心理學的角度去看。舉個例子:節目表示未來太空旅遊住宿可行性,但卻忽略奧客、意外的產生。在地球你可能最壞就是大火、崩塌,來到宇宙恭喜你可能要多買超多憶萬保險,一個拳頭大的隕石打壞設施,可能就會讓你喪命。


我認為這個節目過度樂觀,反倒讓觀眾幫忙憂心起:「真的有你說的那麼順利嗎?」我們看見在全球人臉辨識技術下,中國或其他極權國家反而用這個技術來監控它的人民與意義份子,《未來的》節目所建構下的世界讓我覺得是一個桃源鄉或幻想憧憬下的烏托邦。
但就像諾基亞那句廣告語「科技始終來於人性」,如果需要跟節目上同樣的未來,可能不只科學家或是其他研究者,而是在還沒進到未來前的現在就得開始努力朝向世界想要的未來。如同哲學上的未來是一種以當前狀況和歷史去推斷之後可能會發生的事情,現在與未來是緊密的因果關係,而我們當下種了什麼因,後果就在外來上。


























